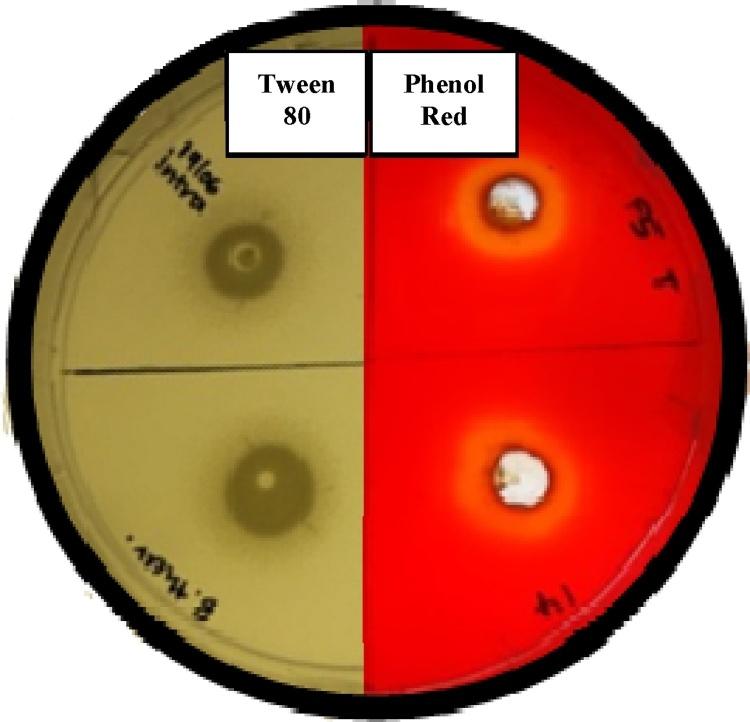

从木材品种的本土细菌中分离出的用于制浆工业的脂解酶的鉴定。
Identification of lipolytic enzymes isolated from bacteria indigenous to wood species for application in the pulping industry.
作者信息
Ramnath L, Sithole B, Govinden R
机构信息
Discipline of Microbiology, School of Life Sciences, College of Agriculture, Engineering and Science, University of KwaZulu-Natal, Westville Campus, P/Bag X54001, Durban 4000, South Africa.
Biorefinery Industry Development Facility, Council for Scientific and Industrial Research, Durban 4000, South Africa.
出版信息
Biotechnol Rep (Amst). 2017 Jul 22;15:114-124. doi: 10.1016/j.btre.2017.07.004. eCollection 2017 Sep.
This study highlights the importance of determining substrate specificity at variable experimental conditions. Lipases and esterases were isolated from microorganisms cultivated from wood species and then concentrated (cellulases removed) and characterized. Phenol red agar plates supplemented with 1% olive oil or tributyrin was ascertained to be the most favourable method of screening for lipolytic activity. Lipolytic activity of the various enzymes were highest at 45-61 U/ml at the optimum temperature and pH of between at 30-35 °C and pH 4-5, respectively. Change in pH influenced the substrate specificity of the enzymes tested. The majority of enzymes tested displayed a propensity for longer aliphatic acyl chains such as dodecanoate (C), myristate (C), palmitate (C) and stearate (C) indicating that they could be characterised as potential lipases. Prospective esterases were also detected with specificity towards acetate (C), butyrate (C) and valerate (C). Enzymes maintained up to 95% activity at the optimal pH and temperature for 2-3 h. It is essential to test substrates at various pH and temperature when determining optimum activity of lipolytic enzymes, a method rarely employed. The stability of the enzymes at acidic pH and moderate temperatures makes them excellent candidates for application in the treatment of pitch during acid bi-sulphite pulping, which would greatly benefit the pulp and paper industry.
本研究强调了在可变实验条件下确定底物特异性的重要性。从木材品种培养的微生物中分离出脂肪酶和酯酶,然后进行浓缩(去除纤维素酶)并进行表征。已确定补充1%橄榄油或三丁酸甘油酯的酚红琼脂平板是筛选脂解活性最有利的方法。各种酶的脂解活性在最佳温度和pH分别为30 - 35°C和pH 4 - 5时最高,为45 - 61 U/ml。pH的变化影响了所测试酶的底物特异性。大多数测试的酶对较长的脂肪酰链如十二烷酸(C)、肉豆蔻酸(C)、棕榈酸(C)和硬脂酸(C)表现出倾向,表明它们可被表征为潜在的脂肪酶。还检测到了对乙酸盐(C)、丁酸盐(C)和戊酸盐(C)具有特异性的潜在酯酶。酶在最佳pH和温度下保持高达95%的活性达2 - 3小时。在确定脂解酶的最佳活性时,在各种pH和温度下测试底物至关重要,而这是一种很少采用的方法。这些酶在酸性pH和适中温度下的稳定性使其成为酸性亚硫酸盐制浆过程中处理树脂的极佳候选者,这将极大地有利于制浆造纸工业。